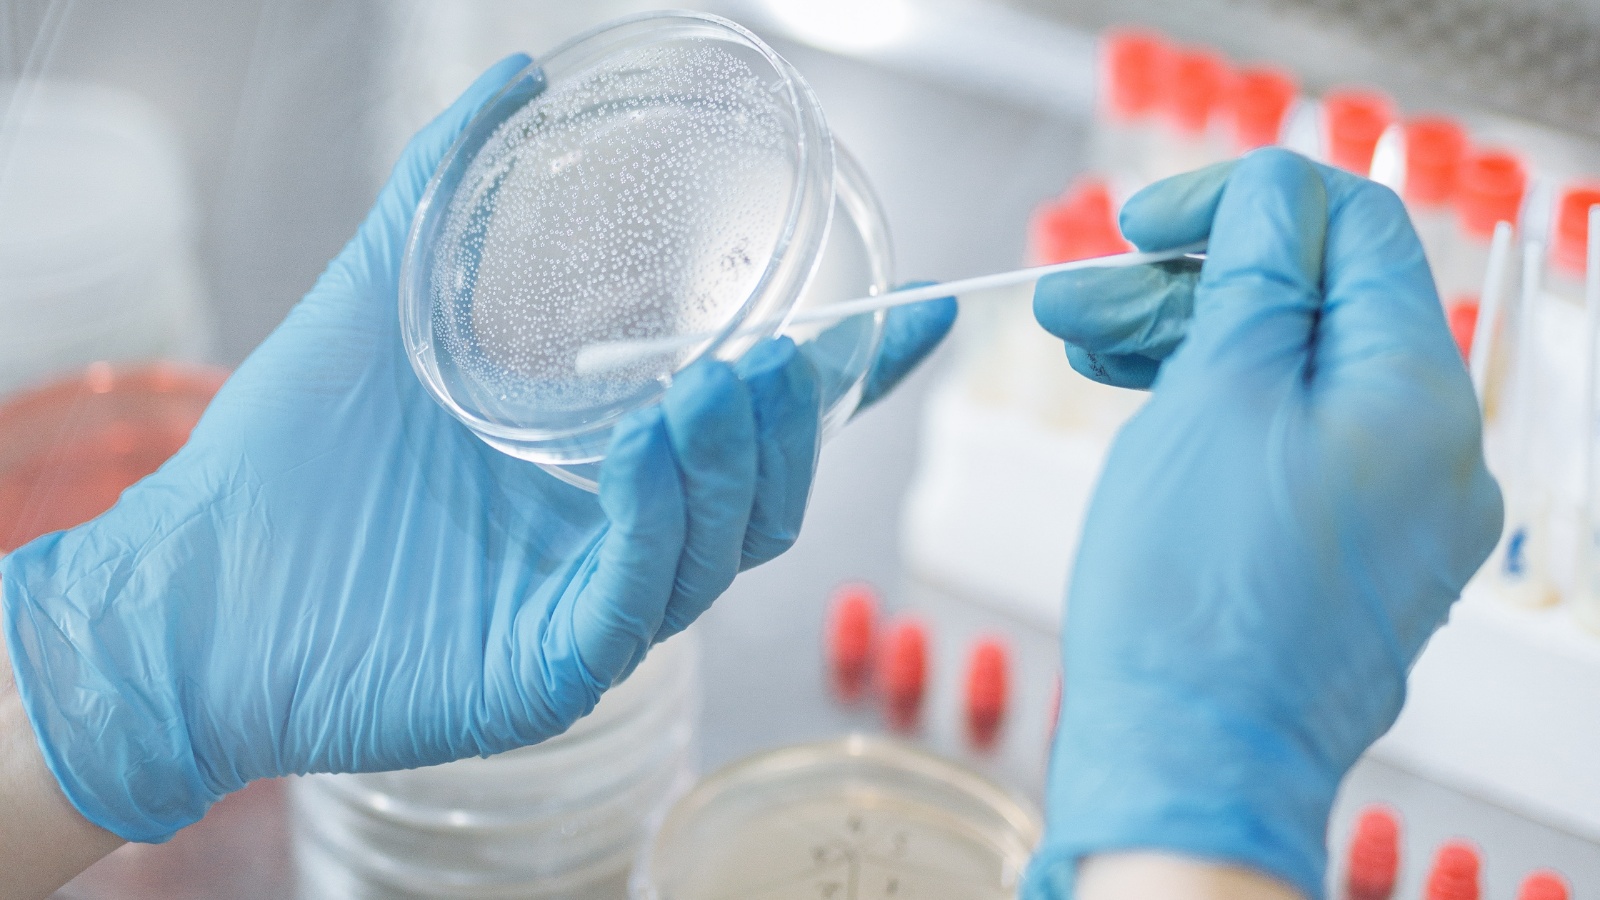

Дали рекомендации по лабораторной диагностике ОРИ, гриппа и COVID-19
Методрекомендации определяют подходы к исследованиям ОРИ, гриппа и COVID-19 в условиях их смешанной циркуляции. Документ поможет не допустить распространения инфекции и провести своевременные противоэпидемические мероприятия.
Грипп, COVID-19, ОРВИ и ОРИ имеют схожие клинические проявления, поэтому при определении диагноза нужно лабораторное подтверждение. Диагностику проводят как при госпитализации, так и при амбулаторном лечении, в первую очередь лицам из групп риска тяжелого течения инфекции.
Делать диагностику рекомендуют в течение 24 ч с момента обращения пациента за медпомощью. Для скрининга можно использовать экспресс-тесты, которые за несколько минут выявляют вирусы.
Описали методы получения биологического материала для исследований при инфекции верхних или нижних дыхательных путей. На этикетке пробирок с материалом пишут его тип, дату отбора, фамилию и имя обследуемого. В сопроводительном документе указывают возраст больного, предполагаемый диагноз, данные о вакцинации и др.
Образцы от каждого пациента упаковывают в герметичный пакет с адсорбентом. Перевозят образцы в термоконтейнерах. Время доставки в лабораторию не должно превышать 24 ч с момента отбора биологического материала. В тот же срок лаборатория выполняет исследование и передает результат в медорганизацию, которая направила материал.
Отметим, что ограничение времени доставки и исследования материала установили с 28 декабря 2022 года.
Публикация подготовлена на основе материалов, поступивших в фонд ГАУ "РМБИЦ",
с использованием справочно-правовой системы "КонсультантПлюс".